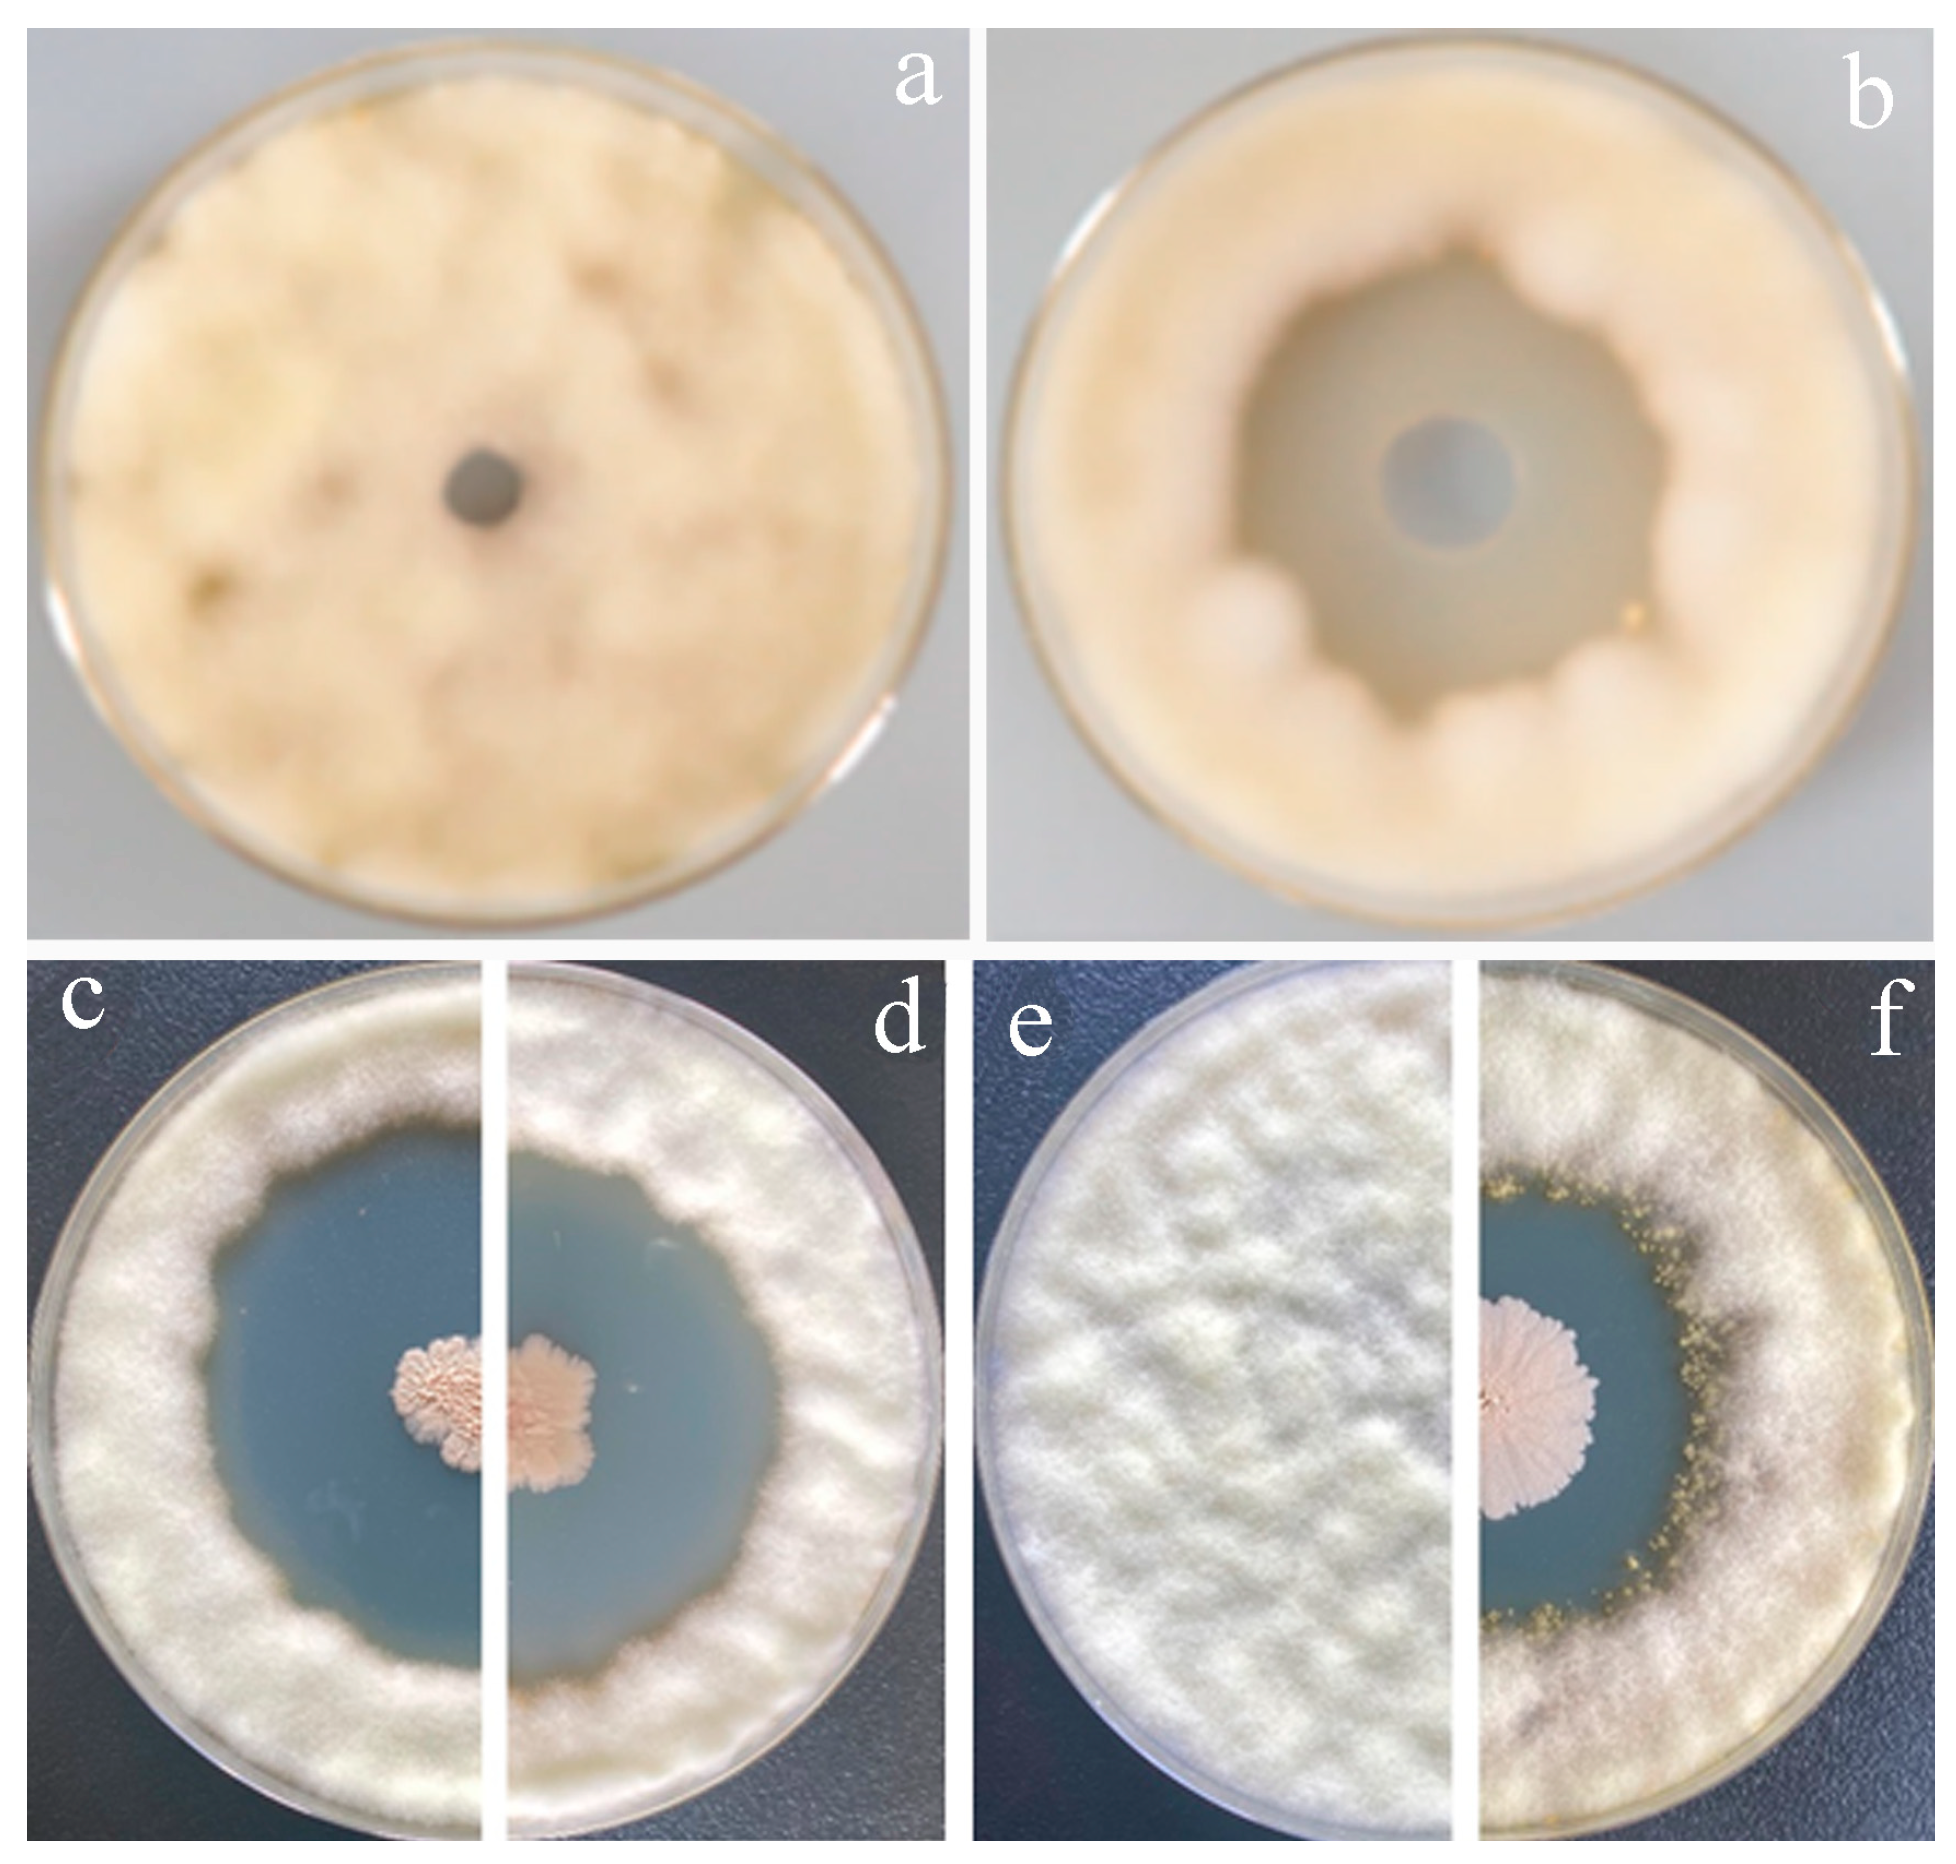
Agronomy 14 02204 g002

Surfactins and Iturins Produced by Bacillus velezensis Jt84 Strain Synergistically Contribute to the Biocontrol of Rice False Smut
Abstract
1. Introduction
2. Materials and Methods
2.1. Strain Materials and Culture Conditions
2.2. Construction of the Surfactin Deletion Mutant Jt84Δsrf
2.3. Crude Extraction of Lipopeptides Produced by B. velezensis Jt84 and Its Mutant Strains
2.4. Detection of Lipopeptides by High-Performance Liquid Chromatography
2.5. Swarming Motility and Floating Biofilm Assays
2.6. Antifungal Activity Assay
2.7. Colonization of Jt84gfp and Mutant Strains on Rice Leaves
2.8. Statistical Data Analysis
3. Results
3.1. Disruption of Srf and Itu Genes Inhibited the Production of Surfactins and Iturins in B. velezensis Strain Jt84 and Its Derivative Mutants
3.2. Antifungal Activity of Lipopeptides, Wild-Type Jt84 Strain, and Mutant Strains
3.3. Evaluation of Biofilm Formation and Swarming Motility of Jt84 and Mutant Strains
3.4. Colonization Dynamics on Rice Leaves of Jt84 and Mutant Strains
4. Discussion
5. Conclusions
Author Contributions
Funding
Data Availability Statement
Conflicts of Interest
Appendix A

References
- Fan, J.; Yang, J.; Wang, Y.Q.; Li, G.B.; Li, Y.; Huang, F.; Wang, W.M. Current understanding on Villosiclava virens, a unique flower-infecting fungus causing rice false smut disease. Mol. Plant Pathol. 2016, 17, 1321–1330. [Google Scholar] [CrossRef] [PubMed]
- Dangi, B.; Khanal, S.; Shah, S. A review on rice false smut, it’s distribution, identiffcation and management practices. Acta Sci. Agric. 2020, 4, 48–54. [Google Scholar] [CrossRef]
- Tanaka, E.; Taketo, A.; Sonoda, R.; Tanaka, C. Villosiclava virens gen. nov., comb. nov., teleomorph of Ustilaginoidea virens, the causal agent of rice false smut. Mycotaxon 2008, 106, 491–501. [Google Scholar]
- Song, J.H.; Wang, Y.F.; Yin, W.X.; Huang, B.J.; Luo, C.X. Effect of chemical seed treatment on rice false smut control in field. Plant Dis. 2021, 105, 3218–3223. [Google Scholar] [CrossRef]
- Liu, L.; Zhao, K.; Cai, L.; Zhang, Y.; Fu, Q.; Huang, S. Combination effects of tebuconazole with Bacillus subtilis to control rice false smut and the related synergistic mechanism. Pest Manag. Sci. 2023, 79, 234–243. [Google Scholar] [CrossRef]
- Hu, Y.; Yang, X.; Tai, B.; Wang, G.; Zhang, X.; Yin, Y.; Xing, F. Bacillus amyloliquefaciens A-1 inhibiting fungal spoilage in agricultural products is improved by metabolic engineering of enhancing surfactin yield. Food Res. Int. 2024, 175, 113752. [Google Scholar] [CrossRef]
- Lam, V.B.; Meyer, T.; Arias, A.A.; Ongena, M.; Oni, F.E.; Hofte, M. Bacillus cyclic lipopeptides iturin and fengycin control rice blast caused by Pyricularia oryzae in potting and acid sulfate soils by direct antagonism and induced systemic resistance. Microorganisms 2021, 9, 1441. [Google Scholar] [CrossRef]
- Li, Y.; Heloir, M.C.; Zhang, X.; Geissler, M.; Trouvelot, S.; Jacquens, L.; Henkel, M.; Su, X.; Fang, X.; Wang, Q.; et al. Surfactin and fengycin contribute to the protection of a Bacillus subtilis strain against grape downy mildew by both direct effect and defence stimulation. Mol. Plant Pathol. 2019, 20, 1037–1050. [Google Scholar] [CrossRef]
- Zeriouh, H.; Romero, D.; Garcia-Gutierrez, L.; Cazorla, F.M.; de Vicente, A.; Perez-Garcia, A. The iturin-like lipopeptides are essential components in the biological control arsenal of Bacillus subtilis against bacterial diseases of cucurbits. Mol. Plant Microbe Interact. 2011, 24, 1540–1552. [Google Scholar] [CrossRef]
- Hoff, G.; Arguelles Arias, A.; Boubsi, F.; Prsic, J.; Meyer, T.; Ibrahim, H.M.M.; Steels, S.; Luzuriaga, P.; Legras, A.; Franzil, L.; et al. Surfactin stimulated by pectin molecular patterns and root exudates acts as a key driver of the Bacillus-plant mutualistic interaction. mBio 2021, 12, e0177421. [Google Scholar] [CrossRef]
- Zalila-Kolsi, I.; Ben-Mahmoud, A.; Al-Barazie, R. Bacillus amyloliquefaciens: Harnessing its potential for industrial, medical, and agricultural applications-a comprehensive review. Microorganisms 2023, 11, 2115. [Google Scholar] [CrossRef] [PubMed]
- Zeriouh, H.; de Vicente, A.; Perez-Garcia, A.; Romero, D. Surfactin triggers biofilm formation of Bacillus subtilis in melon phylloplane and contributes to the biocontrol activity. Environ. Microbiol. 2014, 16, 2196–2211. [Google Scholar] [CrossRef] [PubMed]
- Cochrane, S.A.; Vederas, J.C. Lipopeptides from Bacillus and Paenibacillus spp.: A Gold Mine of Antibiotic Candidates. Med. Res. Rev. 2016, 36, 4–31. [Google Scholar] [CrossRef] [PubMed]
- Luo, C.; Liu, X.; Zhou, H.; Wang, X.; Chen, Z. Nonribosomal peptide synthase gene clusters for lipopeptide biosynthesis in Bacillus subtilis 916 and their phenotypic functions. Appl. Environ. Microbiol. 2015, 81, 422–431. [Google Scholar] [CrossRef] [PubMed]
- Cawoy, H.; Mariutto, M.; Henry, G.; Fisher, C.; Vasilyeva, N.; Thonart, P.; Dommes, J.; Ongena, M. Plant defense stimulation by natural isolates of Bacillus depends on efficient surfactin production. Mol. Plant Microbe Interact. 2014, 27, 87–100. [Google Scholar] [CrossRef]
- Romero, D.; de Vicente, A.; Rakotoaly, R.H.; Dufour, S.E.; Veening, J.W.; Arrebola, E.; Cazorla, F.M.; Kuipers, O.P.; Paquot, M.; Perez-Garcia, A. The iturin and fengycin families of lipopeptides are key factors in antagonism of Bacillus subtilis toward Podosphaera fusca. Mol. Plant Microbe Interact. 2007, 20, 430–440. [Google Scholar] [CrossRef]
- Ley-Lopez, N.; Basilio Heredia, J.; San Martin-Hernandez, C.; Ibarra-Rodriguez, J.R.; Angulo-Escalante, M.A.; Garcia-Estrada, R.S. Induced biosynthesis of fengycin and surfactin in a strain of Bacillus amyloliquefaciens with oomyceticidal activity on zoospores of Phytophthora capsici. Rev. Argent. Microbiol. 2022, 54, 181–191. [Google Scholar]
- Mahmood, T.; Moosa, A.; Ahmad, W.; Malik, J.; Shafiq, M.U.; Yousaf, M.; Anwar, H.; Luqman, M.; Abadin, Z.U.; Abbas, G. Lipopeptides: Powerful antifungal compounds produced by Bacillus species: A review. Plant Prot. 2023, 7, 605–614. [Google Scholar] [CrossRef]
- Pertot, I.; Puopolo, G.; Hosni, T.; Pedrotti, L.; Jourdan, E.; Ongena, M. Limited impact of abiotic stress on surfactin production in planta and on disease resistance induced by Bacillus amyloliquefaciens S499 in tomato and bean. FEMS Microbiol. Ecol. 2013, 86, 505–519. [Google Scholar] [CrossRef]
- Wang, Y.; Zhang, C.; Liang, J.; Wu, L.; Gao, W.; Jiang, J. Iturin A extracted from Bacillus subtilis WL-2 affects Phytophthora infestans via cell structure disruption, oxidative stress, and energy supply dysfunction. Front. Microbiol. 2020, 11, 536083. [Google Scholar] [CrossRef]
- Aleti, G.; Lehner, S.; Bacher, M.; Compant, S.; Nikolic, B.; Plesko, M.; Schuhmacher, R.; Sessitsch, A.; Brader, G. Surfactin variants mediate species-specific biofilm formation and root colonization in Bacillus. Environ. Microbiol. 2016, 18, 2634–2645. [Google Scholar] [CrossRef] [PubMed]
- Luo, C.; Zhou, H.; Zou, J.; Wang, X.; Zhang, R.; Xiang, Y.; Chen, Z. Bacillomycin L and surfactin contribute synergistically to the phenotypic features of Bacillus subtilis 916 and the biocontrol of rice sheath blight induced by Rhizoctonia solani. Appl. Microbiol. Biotechnol. 2015, 99, 1897–1910. [Google Scholar] [CrossRef]
- Vlamakis, H.; Chai, Y.R.; Beauregard, P.; Losick, R.; Kolter, R. Sticking together: Building a biofilm the Bacillus subtilis way. Nat. Rev. Microbiol. 2013, 11, 157–168. [Google Scholar] [CrossRef] [PubMed]
- Gao, S.F.; Wu, H.J.; Yu, X.F.; Qian, L.M.; Gao, X.W. Swarming motility plays the major role in migration during tomato root colonization by SWR01. Biol. Control 2016, 98, 11–17. [Google Scholar] [CrossRef]
- Kraigher, B.; Butolen, M.; Stefanic, P.; Mulec, I.M. Kin discrimination drives territorial exclusion during swarming and restrains exploitation of surfactin. ISME J. 2022, 16, 833–841. [Google Scholar] [CrossRef]
- Mireles, J.R.; Toguchi, A.; Harshey, R.M. Serovar typhimurium swarming mutants with altered biofilm-forming abilities: Surfactin inhibits biofilm formation. J. Bacteriol. 2001, 183, 5848–5854. [Google Scholar] [CrossRef]
- Liu, J.; Li, W.; Zhu, X.Y.; Zhao, H.Z.; Lu, Y.J.; Zhang, C.; Lu, Z.X. Surfactin effectively inhibits Staphylococcus aureus adhesion and biofilm formation on surfaces. Appl. Microbiol. Biotechnol. 2019, 103, 4565–4574. [Google Scholar] [CrossRef]
- Nelson, J.; El-Gendy, A.O.; Mansy, M.S.; Ramadan, M.A.; Aziz, R.K. The biosurfactants iturin, lichenysin and surfactin, from vaginally isolated lactobacilli, prevent biofilm formation by pathogenic. Fems Microbiol. Lett. 2020, 367, fnaa126. [Google Scholar] [CrossRef] [PubMed]
- Bais, H.P.; Fall, R.; Vivanco, J.M. Biocontrol of Bacillus subtilis against infection of Arabidopsis roots by Pseudomonas syringae is facilitated by biofilm formation and surfactin production. Plant Physiol. 2004, 134, 307–319. [Google Scholar] [CrossRef]
- Mo, X.; Fu, Y.; Patel, J.S.; Zhang, S. Surfactin and biofilm production by IN937b, a biological control agent for suppressing phytophthora blight on squash. Phytopathology 2013, 103, 98. [Google Scholar]
- Zhang, Y.; Qi, J.S.; Wang, Y.Q.; Wen, J.H.; Zhao, X.Y.; Qi, G.F. Comparative study of the role of surfactin-triggered signalling in biofilm formation among different Bacillus species. Microbiol. Res. 2022, 254, 126920. [Google Scholar] [CrossRef] [PubMed]
- Kawagoe, Y.; Shiraishi, S.; Kondo, H.; Yamamoto, S.; Aoki, Y.; Suzuki, S. Cyclic lipopeptide iturin A structure-dependently induces defense response in Arabidopsis plants by activating SA and JA signaling pathways. Biochem. Biophys. Res. Commun. 2015, 460, 1015–1020. [Google Scholar] [CrossRef] [PubMed]
- Xu, Z.H.; Mandic-Mulec, I.; Zhang, H.H.; Liu, Y.; Sun, X.L.; Feng, H.C.; Xun, W.B.; Zhang, N.; Shen, Q.R.; Zhang, R.F. Antibiotic bacillomycin D affects iron acquisition and biofilm formation in through a btr-mediated FeuABC-dependent pathway. Cell Rep. 2019, 29, 1192–1202.e5. [Google Scholar] [CrossRef] [PubMed]
- Zhang, R.S.; Wang, F.G.; Qi, Z.Q.; Qiao, J.Q.; Du, Y.; Yu, J.J.; Yu, M.N.; Liang, D.; Song, T.Q.; Yan, P.X.; et al. Iturins produced by Bacillus velezensis Jt84 play a key role in the biocontrol of rice blast disease. Biol. Control 2022, 174, 105001. [Google Scholar] [CrossRef]
- Zhang, R.S.; Yu, J.J.; Qi, Z.Q.; Zhang, H.; Du, Y.; Yu, M.N.; Song, T.Q.; Cao, H.J.; Pan, X.Y.; Yong, M.L.; et al. Study on the field application technology of Bacillus amyloliquefaciens Jt84 against rice false smut. Chin. J. Biol. Control 2021, 37, 525–530. [Google Scholar]
- Yu, J.J.; Yu, M.N.; Song, T.Q.; Cao, H.J.; Pan, X.Y.; Yong, M.L.; Qi, Z.Q.; Du, Y.; Zhang, R.S.; Yin, X.L.; et al. A Homeobox Transcription Factor UvHOX2 Regulates Chlamydospore Formation, Conidiogenesis, and Pathogenicity in Ustilaginoidea virens. Front. Microbiol. 2019, 10, 1071. [Google Scholar] [CrossRef]
- Zhang, R.S.; Liu, Y.F.; Luo, C.P.; Wang, X.Y.; Liu, Y.Z.; Qiao, J.Q.; Yu, J.J.; Chen, Z.Y. Bacillus amyloliquefaciens Lx-11, a potential biocontrol agent against rice leaf streak. J. Plant Pathol. 2012, 94, 609–619. [Google Scholar]
- Romero, D.; Aguilar, C.; Losick, R.; Kolter, R. Amyloid fibers provide structural integrity to biofilms. Proc. Natl. Acad. Sci. USA 2010, 107, 2230–2234. [Google Scholar] [CrossRef]
- Husna; Kim, B.E.; Won, M.H.; Jeong, M.I.; Oh, K.K.; Park, D.S. Characterization and genomic insight of surfactin-producing Bacillus velezensis and its biocontrol potential against pathogenic contamination in lettuce hydroponics. Environ. Sci. Pollut. Res. Int. 2023, 30, 121487–121500. [Google Scholar] [CrossRef]
- Ongena, M.; Jacques, P.; Toure, Y.; Destain, J.; Jabrane, A.; Thonart, P. Involvement of fengycin-type lipopeptides in the multifaceted biocontrol potential of Bacillus subtilis. Appl. Microbiol. Biotechnol. 2005, 69, 29–38. [Google Scholar] [CrossRef]
- Tang, Z.; Cao, X.; Zhang, H. Production of iturin A by Bacillus velezensis ND and its biological control characteristics. J. Basic Microbiol. 2023, 63, 179–189. [Google Scholar] [CrossRef] [PubMed]
- Wang, S.Y.; Herrera-Balandrano, D.D.; Wang, Y.X.; Shi, X.C.; Chen, X.; Jin, Y.; Liu, F.Q.; Laborda, P. Biocontrol ability of the group, for the management of fungal postharvest diseases: A review. J. Agric. Food Chem. 2022, 70, 6591–6616. [Google Scholar] [CrossRef]
- Huang, C.X.; Xu, G.Q.; Wang, L.H.; Zhang, P.; Zhao, P.W.; Zhong, Y. Antagonistic properties and screening of Bacillus velezensis Nhw-B72 against wood fungal decay. Forests 2021, 12, 785. [Google Scholar] [CrossRef]
- Xie, S.S.; Jiang, L.; Wu, Q.; Wan, W.K.; Gan, Y.T.; Zhao, L.L.; Wen, J.J. Maize root exudates recruit OR2-30 to inhibit Fusarium graminearum infection. Phytopathology 2022, 112, 1886–1893. [Google Scholar] [CrossRef]
- Stoll, A.; Salvatierra-Martinez, R.; Gonzalez, M.; Araya, M. The role of surfactin production by Bacillus velezensis on colonization, biofilm formation on tomato root and leaf surfaces and subsequent protection (ISR) against Botrytis cinerea. Microorganisms 2021, 9, 2251. [Google Scholar] [CrossRef] [PubMed]
- Xu, Z.H.; Shao, J.H.; Li, B.; Yan, X.; Shen, Q.R.; Zhang, R.F. Contribution of bacillomycin D in SQR9 to antifungal activity and biofilm formation. Appl. Environ. Microbiol. 2013, 79, 808–815. [Google Scholar] [CrossRef] [PubMed]
- Gastélum, G.; Angeles-Morales, A.; Arellano-Wattenbarger, G.; Coronado, Y.; Guevara-Hernandez, E.; Rocha, J. Biofilm formation and maize root-colonization of seed-endophytic Bacilli isolated from native maize landraces. Appl. Soil Ecol. 2024, 199, 105390. [Google Scholar] [CrossRef]
- Therien, M.; Kiesewalter, H.T.; Auria, E.; Charron-Lamoureux, V.; Wibowo, M.; Maroti, G.; Kovacs, A.T.; Beauregard, P.B. Surfactin production is not essential for pellicle and root-associated biofilm development of Bacillus subtilis. Biofilm 2020, 2, 100021. [Google Scholar] [CrossRef]
- Ongena, M.; Jourdan, E.; Adam, A.; Paquot, M.; Brans, A.; Joris, B.; Arpigny, J.L.; Thonart, P. Surfactin and fengycin lipopeptides of Bacillus subtilis as elicitors of induced systemic resistance in plants. Environ. Microbiol. 2007, 9, 1084–1090. [Google Scholar] [CrossRef]
- Crouzet, J.; Arguelles-Arias, A.; Dhondt-Cordelier, S.; Cordelier, S.; Pršić, J.; Hoff, G.; Mazeyrat-Gourbeyre, F.; Baillieul, F.; Clément, C.; Ongena, M.; et al. Biosurfactants in Plant Protection Against Diseases: Rhamnolipids and Lipopeptides Case Study. Front. Bioeng. Biotechnol. 2020, 8, 1014. [Google Scholar] [CrossRef]
- Salvatierra-Martinez, R.; Arancibia, W.; Araya, M.; Aguilera, S.; Olalde, V.; Bravo, J.; Stoll, A. Colonization ability as an indicator of enhanced biocontrol capacity-an example using two strains and infection of tomatoes. J. Phytopathol. 2018, 166, 601–612. [Google Scholar] [CrossRef]
- Yu, Z.; Wang, D.S.; Zhang, B.; Mao, H.C.; Wang, Z.; Yan, Z.G.; Tao, C.Y.; Deng, X.H.; Shen, Q.R.; Li, R. Bacillus velezensis SQR9 promotes plant growth through colonization and rhizosphere-phyllosphere bacteria interaction. Environ. Microbiol. Rep. 2024, 16, e13250. [Google Scholar] [CrossRef] [PubMed]
- Tang, Z.M.; Zhang, H.L.; Xiong, J.; Li, Y.; Luo, W. Enhanced iturin a production in a two-compartment biofilm reactor by Bacillus velezensis ND. Front. Bioeng. Biotechnol. 2023, 11, 1102786. [Google Scholar] [CrossRef] [PubMed]

| Strains | Description | References |
|---|---|---|
| Jt84 | wild-type, srf+, itu+, fen+ | [34] |
| Jt84gfp | wild-type, srf+, itu+, fen+, Cmr, Jt84 tagged with green fluorescent protein | [34] |
| Jt84∆srf | surfactins mutant: srf−, itu+, fen+, Cmr | This study |
| Jt84∆itu | iturins mutant: itu−, srf+, fen+, Cmr | [34] |
| Ustilaginoidea virens P-1 | rice false smut pathogen | [36] |
Disclaimer/Publisher’s Note: The statements, opinions and data contained in all publications are solely those of the individual author(s) and contributor(s) and not of MDPI and/or the editor(s). MDPI and/or the editor(s) disclaim responsibility for any injury to people or property resulting from any ideas, methods, instructions or products referred to in the content. |
© 2024 by the authors. Licensee MDPI, Basel, Switzerland. This article is an open access article distributed under the terms and conditions of the Creative Commons Attribution (CC BY) license (https://creativecommons.org/licenses/by/4.0/).
Share and Cite
Zhang, R.; Yu, J.; Yang, L.; Qiao, J.; Qi, Z.; Yu, M.; Du, Y.; Song, T.; Cao, H.; Pan, X.; et al. Surfactins and Iturins Produced by Bacillus velezensis Jt84 Strain Synergistically Contribute to the Biocontrol of Rice False Smut. Agronomy 2024, 14, 2204. https://doi.org/10.3390/agronomy14102204
Zhang R, Yu J, Yang L, Qiao J, Qi Z, Yu M, Du Y, Song T, Cao H, Pan X, et al. Surfactins and Iturins Produced by Bacillus velezensis Jt84 Strain Synergistically Contribute to the Biocontrol of Rice False Smut. Agronomy. 2024; 14(10):2204. https://doi.org/10.3390/agronomy14102204
Chicago/Turabian StyleZhang, Rongsheng, Junjie Yu, Lin Yang, Junqing Qiao, Zhongqiang Qi, Mina Yu, Yan Du, Tianqiao Song, Huijuan Cao, Xiayan Pan, and et al. 2024. "Surfactins and Iturins Produced by Bacillus velezensis Jt84 Strain Synergistically Contribute to the Biocontrol of Rice False Smut" Agronomy 14, no. 10: 2204. https://doi.org/10.3390/agronomy14102204
APA StyleZhang, R., Yu, J., Yang, L., Qiao, J., Qi, Z., Yu, M., Du, Y., Song, T., Cao, H., Pan, X., Liu, Y., & Liu, Y. (2024). Surfactins and Iturins Produced by Bacillus velezensis Jt84 Strain Synergistically Contribute to the Biocontrol of Rice False Smut. Agronomy, 14(10), 2204. https://doi.org/10.3390/agronomy14102204

